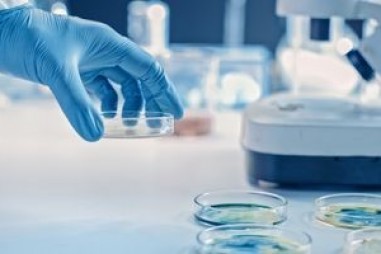
Các nhà khoa học thiết kế Enzyme vi khuẩn  được cho là có khả năng ngăn chặn phản ứng miễn dịch

Thiết kế pin mới giúp giảm nguy cơ cháy nổ
TNNN - Nhóm nghiên cứu từ Đại học Trung văn Hong Kong (CUHK) thay đổi hóa chất trong dung dịch điện phân của pin lithium-ion, giúp pin giữ ổn định...

TNNN - Nhóm nghiên cứu từ Đại học Trung văn Hong Kong (CUHK) thay đổi hóa chất trong dung dịch điện phân của pin lithium-ion, giúp pin giữ ổn định...

TNNN - Phương pháp mới cung cấp các loại thuốc ứng cử viên cho bệnh ung thư, tiểu đường, viêm nhiễm, v.v.

TNNN - Kỹ thuật mới cho phép các nhà nghiên cứu chuyển đổi các gen riêng lẻ điều chỉnh sự tăng trưởng, phát triển và chức năng của tế bào.

TNNN - Kỹ thuật mới sử dụng chụp cắt lớp điện tử và lấy trung bình biểu đồ phụ đã giải quyết được cấu trúc của vỏ bọc vi-rút HIV.
TNNN - Enzyme vi khuẩn được gọi là Lit bị nghi ngờ có vai trò "tàng hình" trong việc giảm phản ứng miễn dịch.

TNNN - Thiết kế phòng thí nghiệm linh hoạt, chu đáo giúp tiết kiệm cả năng lượng và tiền bạc

TNNN - Liệu có thể thiết kế các bề mặt để giảm thời gian tồn tại của vi rút, bao gồm cả vi rút corona gây ra COVID-19?

TNNN - Các hạt nano bắt vi rút SARS-CoV-2 trong cơ thể và sau đó sử dụng hệ thống miễn dịch của chính cơ thể để tiêu diệt nó.

TNNN - Các nhà hóa học Mỹ đã phát triển một nhóm hóa chất chứa Bo bền hơn 10.000 lần so với các nhóm hóa chất tiền nhiệm.

TNNN - Bàn phím mã truy cập hoàn toàn trong suốt ngăn kẻ trộm không nhìn thấy giao diện của hệ thống an ninh.

TNNN - Mục tiêu bao trùm của thiết kế phòng thí nghiệm luôn là sự tích hợp của nhân viên phòng thí nghiệm với thiết bị và vật liệu nguy hiểm. Đại...

TNNN - Thầy và trò Viện Kỹ thuật Hoá học, Đại học Bách Khoa Hà Nội đã chế tạo ra mũ thở khí tươi giúp ngăn chặn virus, giảm nguy cơ mà các bác sĩ...

TNNN - Viện Công nghệ Massachusetts chế tạo thành công loại đồng hồ mới sử dụng các nguyên tử vướng víu để đo thời gian chính xác hơn.

TNNN - Ngoài ngăn nCoV, mũ thở khí tươi do nhóm PGS Phan Trung Nghĩa chế tạo dành cho y bác sĩ, giúp phòng chống Ebola, bạch hầu, giá thành bằng 1/10...

TNNN - Lần đầu tiên đã tạo ra một trong những tác nhân tích cực của roi biển trong phòng thử nghiệm.

TNNN - Phòng cách ly áp lực âm và cơ sở xét nghiệm được thiết kế nhằm ngăn chặn không khí ô nhiễm, mang nhiều mầm bệnh hoặc virus phát tán trong quá...

TNNN – Thuật toán TopoBuilder cho phép xây dựng các protein một cách chủ động, protein này được dùng để tạo ra vaccine virus hợp bào hô hấp (RSV).

TNNN - Tối ưu hóa phòng thử nghiệm mang lại môi trường hoạt động thử nghiệm hiệu quả và nhiều lợi ích tiềm năng.

TNNN - Thiết bị phát điện dùng năng lượng sóng biển đã phổ biến trên thế giới nhưng chưa được sử dụng nhiều tại Việt Nam do các thiết bị này chưa phù...

TNNN - Khẩu trang vải làm từ chất liệu cotton kết hợp với lụa tự nhiên hoặc chiffon có thể ngăn chặn 80 - 99% hạt khí dung chứa virus.

TNNN - Trước tình trạng ánh sáng nhân tạo là thứ ánh sáng không thể thiếu trong đời sống sinh hoạt con người và càng ngày được sử dụng càng nhiều,...

TNNN - TIR lens mới có thể hiệu chỉnh hướng đi của tia sáng để tăng đồng dạng phát sáng, tăng đồng dạng màu, mà vẫn giữ hiệu suất cao.